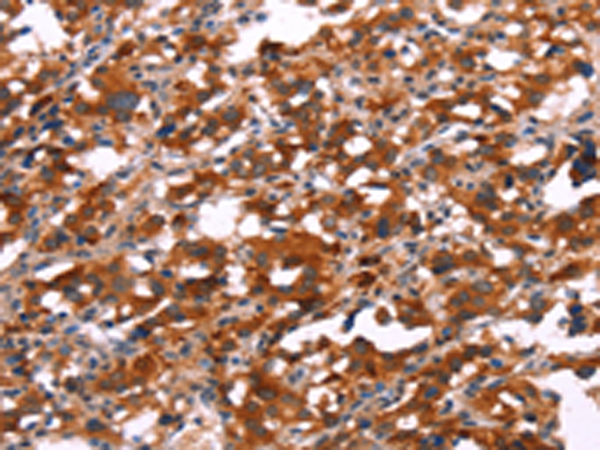
一抗

中文名稱: 兔抗SLC6A1多克隆抗體
英文名稱: Anti-SLC6A1 rabbit polyclonal antibody
別 名: GAT1; GABATR; GABATHG
相關類別: 一抗
儲 存: 冷凍(-20℃)
宿 主: Rabbit
抗 原: SLC6A1
反應種屬: Human, Mouse, Rat
標 記 物: Unconjugate
克隆類型: rabbit polyclonal
技術規格
|
Background: |
The SLC6A1 gene encodes a gamma-aminobutyric acid (GABA) transporter, which removes GABA from the synaptic cleft.The cDNA contained an open reading frame encoding a hydrophobic protein of 599 amino acids with a calculated molecular weight of 67,022 daltons. Hydropathy analysis showed 12 potential transmembrane segments. The human protein is highly homologous to that from rat brain |
|
Applications: |
ELISA, IHC |
|
Name of antibody: |
SLC6A1 |
|
Immunogen: |
Synthetic peptide of human SLC6A1 |
|
Full name: |
solute carrier family 6 (neurotransmitter transporter), member 1 |
|
Synonyms: |
GAT1; GABATR; GABATHG |
|
SwissProt: |
P30531 |
|
ELISA Recommended dilution: |
1000-2000 |
|
IHC positive control: |
Human thyroid cancer and Human gastric cancer |
|
IHC Recommend dilution: |
25-100 |

 購物車
購物車 幫助
幫助
 021-54845833/15800441009
021-54845833/15800441009